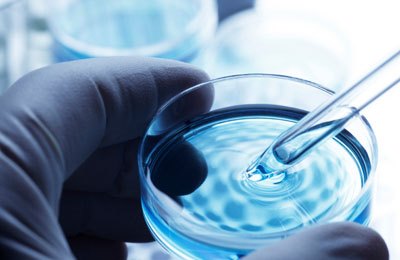

Белый налет и гнойники на миндалинах при отсутствии повышенной температуры у взрослого или ребенка может говорить о двух заболеваниях: ангине или дифтерии.
То, что температура тела нормальная, не считается признаком легкого течения патологии. В некоторых случаях после того, как появляется налет, температура резко поднимается только через несколько дней.
Причины появления
Чаще всего причина белого налета на миндалинах – это острый тонзиллит (ангина), другими словами, воспаление миндалин. Это опасное заболевание, возникающее при понижении иммунитета и проникновении в организм человека вредоносных микроорганизмов.
Ангина по этиологии чаще всего бывает:
вирусная (например, герпетическая);
- бактериальная (стафило-, стрептококковая);
- грибковая (вызванная грибком Candida albicans зачастую);
- смешанные формы.
Фибринозный тонзиллит наиболее ярко выражается появлением белого налета на миндалинах, и поэтому его можно перепутать с дифтерией при отсутствии грамотной диагностики. Также появляются гнойники, содержащие гной, прямо в горле.
Вирусные формы ангин сопровождаются жаром, без температуры протекают крайне редко. Еще одна опасная форма ангины – язвенно-некротическая. Причиной возникновения ее в горле может стать невылеченный кариес зубов. Температура практически не повышается, а налет присутствует. Симптомы такой формы – рвота и спутанное сознание.
Размножение микроорганизмов и их последующее разложение происходит в углублениях в районе гланд, начинается нагноение (собирается гной) и создается пленка – белый налет.
Что касается причин дифтерии, то ее вызывают специфические патогенные бактерии. Они вырабатывают токсический экзотоксин, который является очень ядовитым веществом. Заражение происходит от заболевшего или от носителя инфекции.
Путь передачи – воздушно-капельный. Иногда возможны пищевые вспышки болезни из-за размножения бактерий в молочных продуктах, к примеру.
Белый налет на гландах без повышения температуры может вызывать беспокойство у пациентов. Врачи отмечают, что такая симптоматика может быть связана с различными причинами. Одной из наиболее распространенных является кандидоз, вызванный грибами рода Candida, который часто развивается на фоне ослабленного иммунитета или после приема антибиотиков. Также налет может свидетельствовать о хроническом тонзиллите, когда воспаление гланд становится постоянным. Важно отметить, что в некоторых случаях белый налет может быть признаком аллергической реакции или раздражения слизистой оболочки.
Для диагностики и лечения врачи рекомендуют обратиться к специалисту, который проведет необходимые анализы и определит точную причину. В зависимости от диагноза, лечение может включать противогрибковые препараты, полоскания антисептиками или противовоспалительные средства. Важно не заниматься самолечением, так как неправильный подход может усугубить ситуацию. Регулярные осмотры у врача помогут предотвратить осложнения и поддерживать здоровье глотки.

О чем говорит пленка белого цвета при отсутствии лихорадки?
Налет в горле – это главный признак воспалительного процесса на гландах (также, вполне вероятно, в горле собрался гной). Его наличие говорит о патологии миндалин, которое вскоре может привести к более опасным заболеваниям, например, поражению сердца после тяжело перенесенной ангины.
Отсутствие температуры – скорее плохой, чем хороший, симптом. Так как именно без температуры протекают самые опасные формы любых болезней (в большинстве случаев).
К тому же налет говорит, скорее всего, о гнойном процессе. В мокроте выделяется гной, в горле могут вскрываться гнойники.
Белые точки и пятна на миндалинах – прямой симптом серьезной патологии, лечить которую, видимо, придется довольно долго. Сниженный иммунитет – первоначальная причина того, что появляются подобные патологии, которые сопровождает налет на гландах, гнойники и гной в мокроте.
Именно поэтому внимание к своему здоровью должно быть усиленным, особенно в осенне-зимний период. Комплекс Иммунити – это препарат на основе целебных трав и витаминов, который подходит для всей семьи и защищает организм от простуд, поднимая его иммунные функции.
Диагностика проблемы
Главная диагностика при наличии данного явления на миндалинах – это взятие материала на гландах для дальнейшего микробиологического исследования. Таким образом, уточняется природа патогенных микроорганизмов в горле – грибки это, бактерии или вирусы.
Без данного этапа дальнейшее лечение невозможно.
Для диагностики дифтерии, которую тоже характеризует белая пленка на гландах, важно проверить гемограмму, а также провести бактериологическое исследование выделений из очага воспалительного процесса.
Посев материала должен быть произведен не позже, чем через 3-4 часа после его взятия у больного.
Внимание! До подтверждения какого-либо диагноза нельзя заниматься самолечением.
Поэтому своевременное обращение к профессиональному доктору – первый и самый важный шаг в правильной терапии серьезного заболевания. Гнойники, к примеру, грозят очень страшными последствиями, если после их самопроизвольного вскрытия гной попадет в нижние дыхательные пути.
Белый налет на гландах без повышения температуры может вызывать у людей беспокойство и множество вопросов. Многие связывают его с инфекциями, такими как тонзиллит или фарингит, однако не всегда это так. Часто налет может быть следствием грибковых инфекций, например, кандидоза, или аллергических реакций. Также он может появляться при сухом воздухе или недостаточной гигиене полости рта.
Лечение зависит от причины появления налета. Важно обратиться к врачу для точной диагностики. В некоторых случаях достаточно полоскания солевым раствором или антисептиками, в других — могут потребоваться противогрибковые или антибактериальные препараты. Не стоит игнорировать этот симптом, так как он может сигнализировать о более серьезных проблемах со здоровьем. Регулярная гигиена и поддержание иммунной системы в тонусе помогут предотвратить появление налета в будущем.

Лечение различных состояний
Лечение дифтерии при поражениях на миндалинах происходит зачастую в стационаре. Все больные должны быть немедленно госпитализированы. Больному вводят антитоксическую специальную антидифтерийную сыворотку. Это способствует нейтрализации опасного токсина.
Дезинтоксикационная терапия при дифтерии проводится коллоидными растворами. Иногда вводят глюкокортикостероиды. Плазмафарез проводят при комбинированной форме патологии.
Лечение ангин можно проводить в домашних условиях. При вирусной этиологии применяют противовирусные препараты (например, интерферон).
Очень важно проводить полоскания и орошения горла антисептическими и прочими растворами. Бактериальная ангина лечится с помощью антибиотиков, курс терапии составляет обычно 10 дней.
Параллельно обязательно «прикрывают» антибиотикотерапию лактобактериями или Нистатином для профилактики патологий кишечника, молочницы и других грибковых заболеваний, связанных с дисбактериозом.
Важно! Если в наличии – гнойники в горле, то полоскания проводятся чаще, до десяти раз в день. Содовые растворы хорошо «вытягивают» гной.
Грибковая ангина (сосредоточение вредоносного грибка на миндалинах) – довольно тяжелая патология. Лечат ее антигрибковыми препаратами. Орошения, полоскания и использование спреев остается важным (чтобы «вымыть» имеющийся гной при его наличии).
Любая терапия при ангине должна быть назначена или одобрена лечащим врачом, особенно если речь идет о здоровье ребенка.
Параллельно человеку поднимают иммунитет: применяют витаминотерапию, иммуномодуляторы и прочие лекарства.
Соблюдают постельный режим, диету с содержанием достаточного количества микроэлементов и здоровый сон.
Белый налет, гнойники, белые пятна и точки на слизистой оболочке – только признаки болезни, поэтому после лечения основного заболевания они пройдут сами собой. Осложнения, которыми грозит ангина, предотвращаются с помощью кардиоподдерживающей терапии.
Профилактика появления проблем
Белые точки или пятна на миндалинах не возникают сами по себе. Их появление провоцирует развитие патологии горла, которая в своей основе имеет заражение микроорганизмами и сниженный иммунитет. Поэтому профилактика состоит в поддержке нормального иммунитета и соблюдении здорового образа жизни.
Главные меры профилактики:
отсутствие стрессов;
- правильный трудовой режим;
- иммунотерапия в периоды эпидемий простудных заболеваний;
- внимательность к первым признакам патологий;
- регулярные осмотры у доктора;
- витаминотерапия;
- нормальное питание.
Это не весь перечень, но описать все составляющие здорового образа жизни в нескольких словах невозможно.
Курение и алкоголизм значительно влияют на здоровье и снижают иммунитет.
Остальные вредные привычки, а также нервная обстановка способствуют не только развитию патологий, но и развитию осложнений в виде миокардита, ревматизма и других опасных болезней.
https://youtube.com/watch?v=2ouf5mVH5Do
Вопрос-ответ
Что может вызвать белый налет на гландах без повышения температуры?
Белый налет на гландах без жара может быть вызван несколькими факторами, включая грибковые инфекции, такие как кандидоз, бактериальные инфекции, аллергические реакции или раздражение слизистой оболочки. Также это может быть связано с сухостью во рту или недостаточной гигиеной полости рта.
Как можно лечить белый налет на гландах?
Лечение белого налета на гландах зависит от причины его появления. В случае грибковой инфекции могут быть назначены противогрибковые препараты, а при бактериальных инфекциях — антибиотики. Также важно поддерживать гигиену полости рта, полоскать горло антисептическими растворами и употреблять достаточное количество жидкости.
Когда стоит обратиться к врачу при наличии белого налета на гландах?
Обратиться к врачу следует, если белый налет на гландах сохраняется более нескольких дней, сопровождается дискомфортом, болью при глотании или другими симптомами, такими как отек или затрудненное дыхание. Специалист сможет провести диагностику и назначить соответствующее лечение.
Советы
СОВЕТ №1
Обратите внимание на гигиену полости рта. Регулярная чистка зубов и языка, а также использование ополаскивателей помогут предотвратить накопление бактерий и налета на гландах.
СОВЕТ №2
Пейте достаточное количество жидкости. Увлажнение горла помогает снизить вероятность появления налета и способствует выведению токсинов из организма.
СОВЕТ №3
Не игнорируйте симптомы. Если белый налет на гландах сопровождается неприятным запахом изо рта, болью или дискомфортом, обратитесь к врачу для диагностики и назначения лечения.
СОВЕТ №4
Изучите возможные аллергены и раздражители. Иногда белый налет может быть вызван аллергическими реакциями или воздействием химических веществ, поэтому стоит обратить внимание на окружающую среду и продукты, которые вы употребляете.

вирусная (например, герпетическая);

отсутствие стрессов;